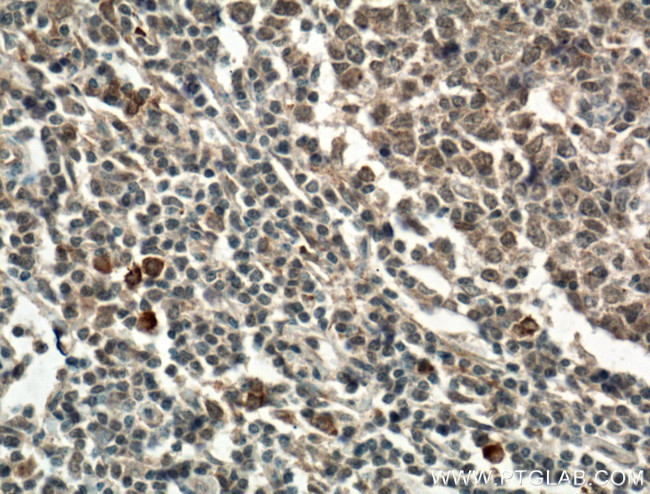
L-selectin Antibody in Immunohistochemistry (Paraffin) (IHC (P))

Search
Proteintech
L-selectin Polyclonal Antibody
{{$productOrderCtrl.translations['antibody.pdp.commerceCard.promotion.promotions']}}
{{$productOrderCtrl.translations['antibody.pdp.commerceCard.promotion.viewpromo']}}
{{$productOrderCtrl.translations['antibody.pdp.commerceCard.promotion.promocode']}}: {{promo.promoCode}} {{promo.promoTitle}} {{promo.promoDescription}}. {{$productOrderCtrl.translations['antibody.pdp.commerceCard.promotion.learnmore']}}
产品信息
26477-1-AP
种属反应
宿主/亚型
分类
类型
抗原
偶联物
形式
浓度
规格
纯化类型
保存液
内含物
保存条件
运输条件
产品详细信息
Immunogen sequence: SSQCAFSCS EGTNLTGIEE TTCGPFGNWS SPEPTCQVIQ CEPLSAPDLG IMNCSHPLAS FSFTSACTFI CSEGTELIGK KKTICESSGI WSNPSPICQK LDKSFSMIKE GDYNPLFIPV AVMVTAFSGL AFIIWLARRL KKGM (233-375 aa encoded by B C020758)
靶标信息
The human CD62L is a 74-95 kDa glycoprotein member of the selectin family of adhesion receptors. L-Selectin is comprised of an aminoterminal C-type lectin binding domain, an epidermal growth factor-like domain, two short consensus repeat (SCR) sequences homologous to those found in complement binding proteins, a short spacer region, a transmembrane region and a short cytoplasmic region. Human CD62L (L-Selectin) is constitutively expressed on all classes of leukocytes including lymphocytes (except a substantial population of memory T cells), monocytes and polymorphonuclear cells.
仅用于科研。不用于诊断过程。未经明确授权不得转售。
生物信息学
蛋白别名: CD62 antigen-like family member L; CD62L; gp90-MEL; hLHRc; L-selectin; LAM-1; LECAM1; Leu-8; Leukocyte adhesion molecule 1; Leukocyte surface antigen Leu-8; Leukocyte-endothelial cell adhesion molecule 1; Lymph node homing receptor; lymph node homing receptor precursor; lymphocyte adhesion molecule 1; pln homing receptor; TQ1; unnamed protein product
基因别名: CD62L; LAM1; LECAM1; LEU8; LNHR; LSEL; LYAM1; PLNHR; SELL; TQ1
UniProt ID: (Human) P14151
Entrez Gene ID: (Human) 6402